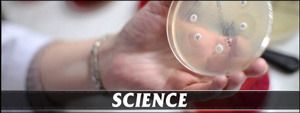

Water No.8
- This is one shoot in cycle “Nature – Water”
- HD – 1920×1080
- 29,97 fps
- this is one clip – duration 00:49
- 892 mb
- Thank you for purchasing my clip and I would be very grateful for rating my clip. The high place in ranking would help me providing Envato with more valuable videos.
Music in preview by “Adigold” can be found here
If you have any questions about this clip, feel free to write me an email. Please rate if you want!
Thank you for the purchase! Enjoy!